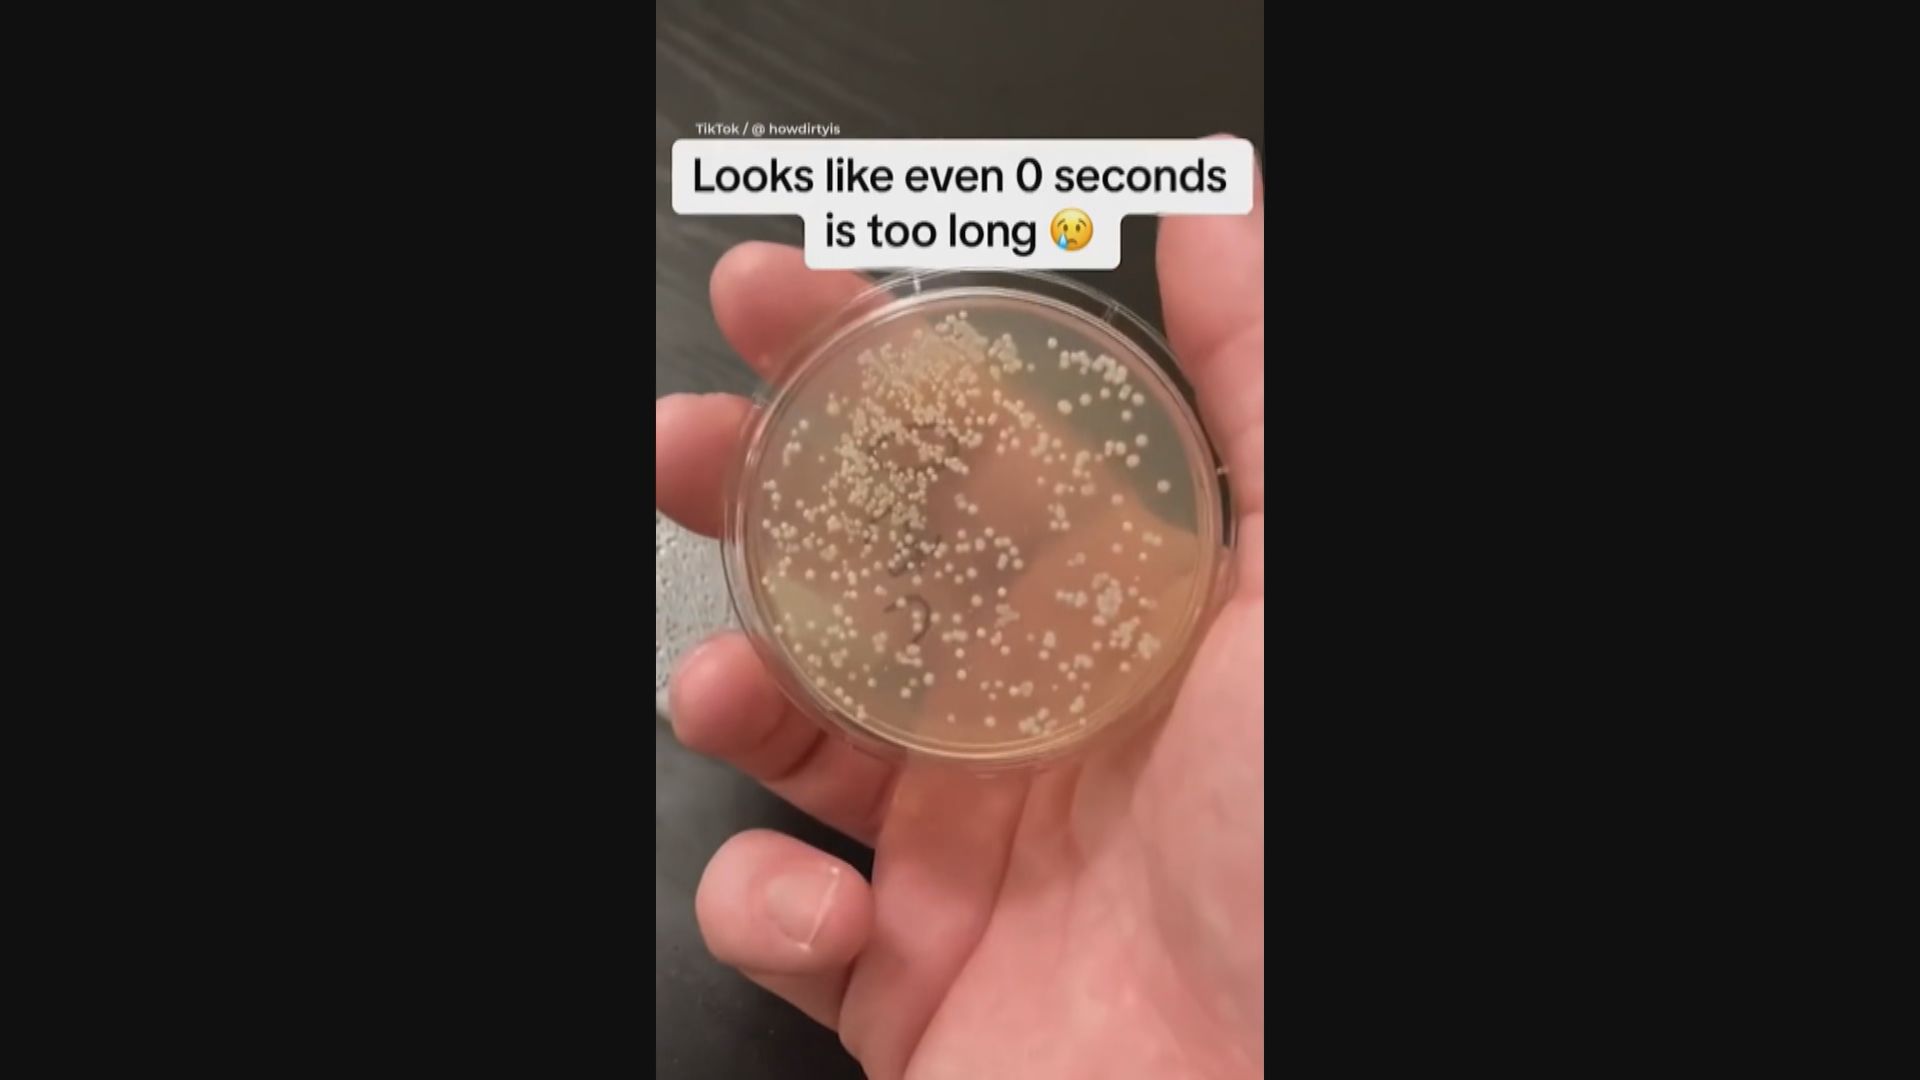
美國微生物學家拆解食物落地「五秒定律」迷思

抱歉,我們並不支援你正使用的瀏覽器。
為達至最佳瀏覽效果,請更新至最新的瀏覽器版本。
如有問題,歡迎電郵至 pccwmediaiapps@pccw.com 查詢。
為達至最佳瀏覽效果,請更新至最新的瀏覽器版本。
如有問題,歡迎電郵至 pccwmediaiapps@pccw.com 查詢。
廣告
【Now新聞台】坊間流傳食物如果掉在地上不超過三秒,便不會被污染可以照吃,有人說五秒甚至七秒也可以,美國一個微生物學家做實驗拆解這個迷思。
曾檢測過飛機、戲院座位,甚至試身室有多少細菌的微生物學家艾徹,這次驗證都市傳說「五秒定律」,他用五個培養皿來模擬食物掉在地上,隔一陣子撿起來吃,會有多少細菌,第一個樣本碰地就馬上撿起,其餘就分別放置了5秒、10秒、20秒、30秒和1分鐘。
艾徹之後將樣本放進培養箱,觀察有多少細菌繁殖,發現就算只是一刹那,已經有大量細菌滋生,放多5至15秒數量都是差不多,30秒的樣本看起來明顯有多些細菌,但放了1分鐘的細菌數量又竟然與5秒相若,艾徹得出的結論是「 0秒也嫌太久」,即是最好不要掉落地。
他的片段在網上流傳,已有超過百萬人觀看,有網民說看完之後食物掉在地上不敢再撿起來吃,亦有人笑言如果隻眼開隻眼閉,就可以繼續奉行「五秒定律」。
有報道指,地板甚至廚房桌面都充滿細菌,沙門氏菌和李斯特菌等會繁殖甚至釋出毒素,如果吃了受污染的食物可以引起腸胃不適,嚴重的可以致命。


